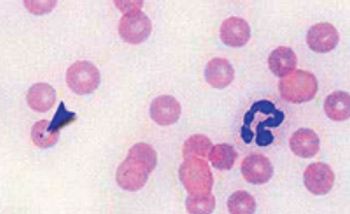
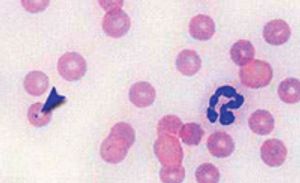
Fig3_Bgibsoni-740180-1384182556403.jpg

Are you on the fence about putting in the extra work to receive those three little letters? This expert says it's worth your time.
Melissa Andrasik, BS, RVT, is an adjunct instructor for Maple Woods Veterinary Technology Program in Kansas City, Mo.

Are you on the fence about putting in the extra work to receive those three little letters? This expert says it's worth your time.

Regardless of whether you work in the front or the back of the clinic, you can play a vital role in identifying and preventing hemoparasitic infections.

Read on for tips to help you prepare a readable blood smear and identify what you see.
September 1st 2011

September 6th 2011

October 12th 2011